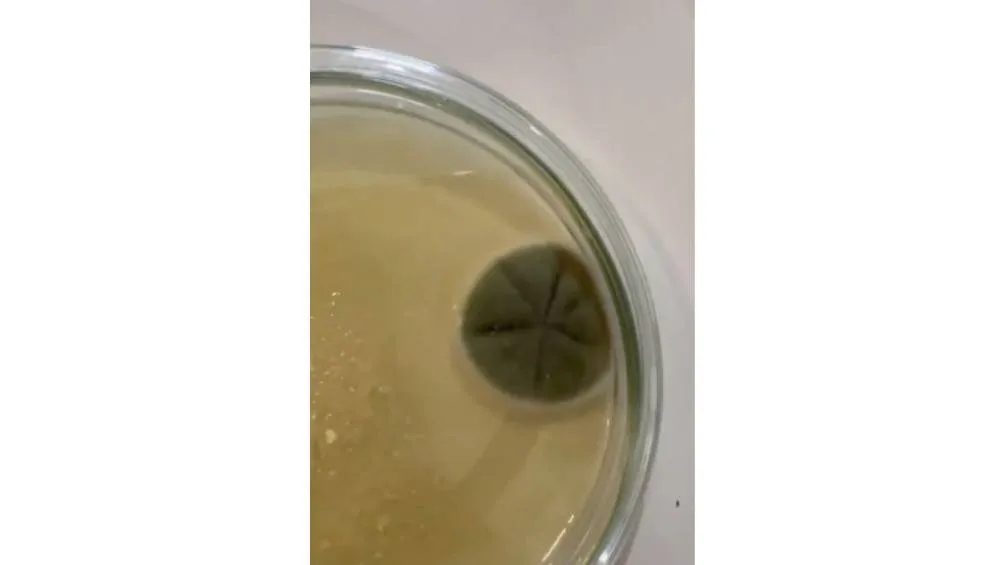
El video ha dejado un sin fin de comentarios. | Captura de pantalla

Un video de TikTok muestra un análisis de microbios en el Metro de la Ciudad de México, donde se hallaron diversas especies de hongos. Dado el alto flujo de personas, se considera un lugar de riesgo para la propagación de enfermedades. En respuesta, un grupo de jóvenes biólogos llevó a cabo un experimento para medir los microorganismos en torniquetes, puertas, tubos y andenes del metro.

Video de TikTok muestra los microbios en el Metro de la Ciudad de México
El 22 de enero, la cuenta de TikTok "Pregúntale al Biólogo" subió un video de recolección de muestras en el Metro de la Ciudad de México, utilizando cajitas de Petri para analizar superficies como torniquetes y taquillas automáticas. El video resultante, que muestra la cantidad de microbios, gérmenes y hongos presentes en el transporte público, ha generado gran sorpresa y revuelo entre los usuarios de redes sociales.
@preguntalealbiologo Los microbios del metro de CDMX … Algunas cosas que debes saber:El medio de cultivo es agar papa dextrosa por lo que los microbios que crecieron son principalmente HONGOS Que hayan crecido estos microbios, no significa que sean necesariamente patogenos. Para más experimentos síguenos en @preguntalealbiologo #c#cienciaentiktokc#cdmxm#metro sonido original - Pregúntale al Biólogo
Aunque no todos los microorganismos son peligrosos, los resultados han generado interés en redes sociales. En un video de 12 segundos, se muestra la recolección de microbios en el Metro de la capital, donde se identificaron diversas especies de hongos, con aproximadamente cinco tipos diferentes al final del clip.
- Yo siempre traigo desinfectante y agarro todo eso con papel de baño.
- Ah, pero hasta comiendo nos subimos.
- Por eso a usar gel cuando uno baje o toque cosas públicas.
- Pues qué esperaban.
- Estaría genial que analizaras las muestras de los taquitos de afuera.
- Deben de limpiar las máquinas y las instalaciones.
- Todas las cosas en el mundo tienen microbios.